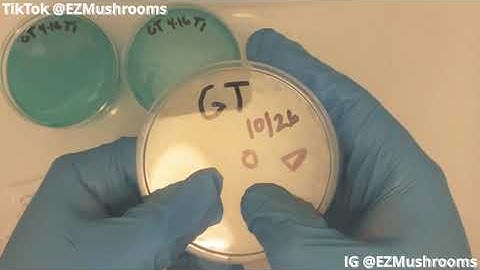
Agar Transfers how to, SAB, From MSS (Agar Files) #Mycology #Mushrooms #GT

⬇ DOWNLOAD NOW
Jika muncul iklan pop-up, tutup lalu klik tombol kembali
Download lagu Sporeswabs on Agar - The Agar Files secara gratis hanya untuk keperluan promosi. Dukung artis favorit kamu dengan membeli musik original di iTunes atau platform resmi lainnya.
 Spore Syringe to Agar - The Agar Files
Spore Syringe to Agar - The Agar Files The Agar Files - Spore Print to Agar (Intro to Agar)
The Agar Files - Spore Print to Agar (Intro to Agar) Spores to Agar Progress ( Time-lapse )
Spores to Agar Progress ( Time-lapse ) Easy Spore Swab Techniques
Easy Spore Swab Techniques Spore to Agar update: Was it successful?
Spore to Agar update: Was it successful? How to: Spore Swab to Agar
How to: Spore Swab to Agar Spore swab to Agar, How to use
Spore swab to Agar, How to use Agar Transfers how to, SAB, From MSS (Agar Files) #Mycology #Mushrooms #GT
Agar Transfers how to, SAB, From MSS (Agar Files) #Mycology #Mushrooms #GT